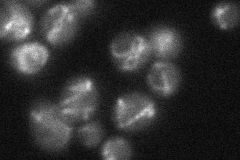
YOR130C
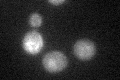
YOR130C

View description
Ornithine transporter of the mitochondrial inner membrane, exports ornithine from mitochondria as part of arginine biosynthesis; human ortholog is associated with hyperammonaemia-hyperornithinaemia-homocitrullinuria (HHH) syndrome
Localization:
Intensity:
Fold change:
Significance:
-
C’ GFP library in SD

mitochondria18.85 -
N' NOP1pr-GFP in SD

mitochondria53.9475 -
N' TEF2pr-mCherry in SD

mitochondria33.0078 -
N' NATIVEpr-GFP in SD
mitochondria31.9768 -
N' TEF2pr-VC and Cyto-VN in SD

#N/A0 -
C’ GFP library in SD+DTT
mitochondriaN/AN/AYes -
C’ GFP library in SD+H2O2

mitochondriaN/AN/AYes -
C’ GFP library in Starvation Media

mitochondriaN/AN/AYes -
C’ GFP library on the background of Pup2-DaMP

N/A -
C’ GFP library on the background of CCT mutant

N/A0N/AYes
